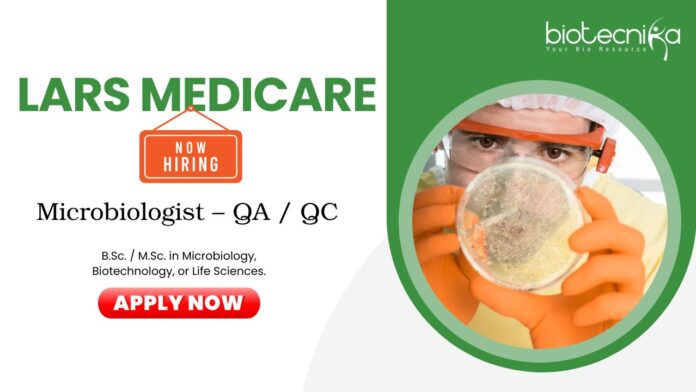

Microbiologist Jobs at Lars Medicare | Life Science Candidates Apply Now
Looking for high-growth Microbiologist jobs in a globally recognized medical device company? Lars Medicare Pvt. Ltd. is hiring skilled QA/QC Microbiologists for its advanced manufacturing facility in Sonipat, Haryana. This life science job is a great opportunity for candidates aiming to build a strong career in life science while working with ISO-certified and CE-marked manufacturing systems.
- Job Role: Microbiologist – QA / QC
- Location: Sonipat, Haryana
About the Company
Lars Medicare Pvt. Ltd. is a leading manufacturer of IV Cannula and a diverse range of Medical Disposable Devices such as Safety IV Cannula, Three Way Stop Cock, Three Way Stop Cock with Extension Tube, IV Extension line, IV Flow Regulator, Infusion Set, Blood Transfusion Set, Measured Volume Set and Needle Free connector, and many more. The Marketing Office is located in Delhi as well as in Canada. The Plant is located in Sonipat, Haryana. Operations and activities are accredited with ISO Certification and CE marked products. The company product lines are available in 100+ countries worldwide.
Key Responsibilities:
- Conduct microbiological monitoring of cleanrooms and controlled environments (air sampling, settle plates, surface swabs, and personnel monitoring).
- Ensure adherence to ISO Class requirements and maintain sterility levels as per company and regulatory standards.
- Perform routine microbial testing of purified water, raw materials, and finished goods.
Qualifications & Skills
- Education: B.Sc. / M.Sc. in Microbiology, Biotechnology, or Life Sciences.
- Experience: 2–5 years of experience in microbiological testing, preferably in medical device, pharmaceutical, or biotechnology manufacturing.
Pay: ₹20,000.00 – ₹40,000.00 per month
Working Conditions
- Laboratory-based role within a controlled and cleanroom environment.
- Requires adherence to safety, hygiene, and gowning protocols.
- Close coordination with Quality Assurance and Production departments.
Interview Details
- Mode: Virtual
- A total of 3 rounds will be there.
If you are looking to grow your career in life science with a globally recognized medical device manufacturer, this microbiologist job at Lars Medicare Pvt. Ltd. is an excellent fit. With strong QA/QC exposure and international-standard operations, the role offers both stability and growth.